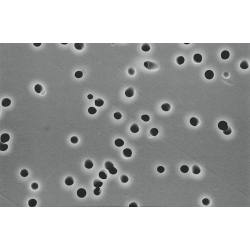
サムネイル

(販売終了品) ポリカーボネートタイプメンブレンフィルタ K080A025A (100枚)
コード:3-314-0181
標準納期日数
こちらの商品は販売を終了しました
同じシリーズの商品が 20 商品あります。
| 商品画像 | 商品番号 | 商品名 | 標準価格 (税抜) |
在庫 | 数量 | |
|---|---|---|---|---|---|---|
| 3-314-0181 | ポリカーボネートタイプメンブレンフィルタ K080A025A (100枚) |
標準価格 販売終了 |
在庫 -- |
|||
| 3-314-0175 | ポリカーボネートタイプメンブレンフィルタ K020A025A (100枚) |
標準価格 ¥24,420 |
在庫 取寄品 |
数量
|
||
| 3-314-0174 | ポリカーボネートタイプメンブレンフィルタ K020A013A (100枚) |
標準価格 販売終了 |
在庫 -- |
|||
| 3-314-0173 | ポリカーボネートタイプメンブレンフィルタ K010A047A (100枚) |
標準価格 販売終了 |
在庫 -- |
|||
| 3-314-0172 | ポリカーボネートタイプメンブレンフィルタ K010A025A (100枚) |
標準価格 販売終了 |
在庫 -- |